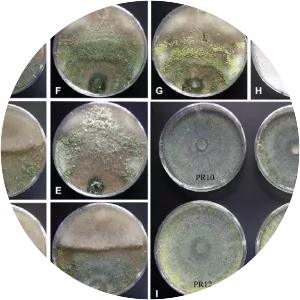
Trichoderma asperellum -

Trichoderma Stromaticum
| Use attributes for filter ! | |
| Genus | Trichoderma |
|---|---|
| Order | Hypocreales |
| Rank | Species |
| Date of Reg. | |
| Date of Upd. | |
| ID | 2102876 |
About Trichoderma Stromaticum
Trichoderma stromaticum is a species of fugus in the family Hypocreaceae. It is a parasite of the cacao witches broom pathogen and has been used in its biological control.